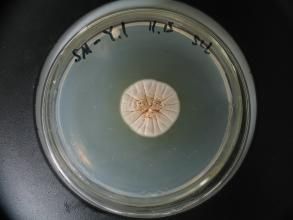
卷枝毛霉 卷枝毛霉

卷枝毛霉
采 集 地 河北 (141, 184),內蒙古 (184),東北 (489),甘肅 (184),寧夏 (184),新疆 (184),江蘇 (184),浙江 (184),江西 (184),湖北 (184),湖南 (184),廣東 (184),四川 (184),貴州 (184),雲南 (184)
編 號 PR9.00114
卷枝毛霉,屬毛霉目,毛霉科,拉丁名為Mucor circinelloides。
采 集 地 河北 (141, 184),內蒙古 (184),東北 (489),甘肅 (184),寧夏 (184),新疆 (184),江蘇 (184),浙江 (184),江西 (184),湖北 (184),湖南 (184),廣東 (184),四川 (184),貴州 (184),雲南 (184)
編 號 PR9.00114
毛霉目( Mucorales) ,接合菌綱中最大、最重要的 1目。通常菌絲體發達、多核、無隔,少數比較高等的類型也可在一開始就形成隔膜。氣生菌絲體往往生...
毛霉目 各科的主要區別性 生物學特性articles)內容索引條目分類目錄說明一、條目分類目錄供了解生物科學的知識體系,查閱一個分支或一個知識主題的有關條目之用。 在細胞的標題下查到“細胞...
作品目錄內容介紹《中國氣傳真菌彩色圖譜》內容包括:空氣中的真菌、總狀毛霉、卷枝毛霉、匍枝根霉、米根霉、華根霉、少根根霉、根霉屬、分枝犁頭霉、藍色犁頭霉、傘枝犁頭霉、犁頭霉屬、繖形卷霉、雅致放射毛霉、刺孢小克銀漢霉等。 ...
內容介紹。 糞生真菌在糞便上出現往往有一定的順序,其演替一般是從毛霉目開始,毛霉屬、水玉霉屬、卷霉屬、梳霉屬、根霉屬在新鮮的糞上於實驗室培養的第2~4天就出現子實體並產生孢子,6天后出現卷枝霉屬、小克銀漢霉等,然後出現毛霉...
上梳霉 相關連線,6天后出現卷枝霉屬、小克銀漢霉等,然後出現毛霉目的重寄生菌集珠霉屬、頭珠霉屬等,它們一般在毛霉目培養8天之內出現,持續 4~6天。不完全菌類...往往有一定的順序,其演替一般是從毛霉目開始,毛霉屬、水玉霉屬、卷霉屬、梳...
簡介 分類 成長過程研究領域[1] 功能性脂質的生物合成及其分子機制:以產脂微生物為模型研究脂質合成/積累的分子機制;重要功能性脂質...
研究領域 學習經歷 科研項目 教學經歷 代表性論文簡介在分類上,內生菌根真菌屬接合菌的毛霉目(Mu-corales)內囊...:中國農業百科全書·生物學卷VA菌根VA菌根(Vesicalar-Arbuscular,即泡囊-叢枝菌根,又稱叢枝菌根),是內囊霉科...
簡介 同植物的關係 VA菌根與植物的礦質營養鐮刀菌匐枝根霉總狀毛霉局限麴黴阿姆斯特丹麴黴煙麴黴...邊螟褐飛虱白背飛虱灰飛虱稻縱卷葉螟顯紋縱卷葉螟黑...卷葉螟豆突眼長蝽豆小捲葉蛾篩豆龜蝽四紋豆象二條葉甲...
內容介紹 作品目錄